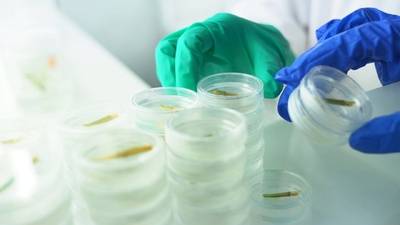

蜀南竹海竹笋(罗先尧 摄)
四月,当清晨第一缕阳光穿透蜀南竹海的薄雾,宜宾市长宁县双河镇竹农彭永贵正麻利地在林下收割一茬茬旺盛的鲜笋。“现正值春笋上市,赶紧收能卖个好价钱。去年我家20多亩竹林,光卖笋就赚了6万元!”他擦了把汗笑道。不远处,满载竹材的3辆卡车正驶向宜宾纸业的原料基地……

蜀南竹海景区
作为“中华竹都”,近年来,宜宾正以“全竹利用”理念重塑产业格局,推动竹产业建圈强链,实现了从“卖原竹”向“卖制品”再到“卖生态”的跨越式发展。截至目前,全市现有竹资源面积334万亩、居全省第二;2024年竹业综合产值实现422.8亿元,居全省第一。
破局:
从“大资源”到“强链条”的转型发展

蜀南竹海拜寿台(龙亿江 摄)
“过去砍竹子卖原料,一吨才赚几百元,现在搞旅游、做深加工、出口等,一根竹子的价值能翻几十倍。”在长宁县蜀南竹海景区,经营竹工艺品的商户朱芳如告诉记者。这样的直观感受,正是宜宾近年来大力发展竹产业链的幸福举证。
宜宾竹林资源丰富,产业基础扎实,竹业综合产值已连续六年蝉联全省第一。按照全省农产品精深加工建圈强链工作部署,宜宾制定了《竹产业建圈强链发展规划(2025-2027)》《2025年竹产业建圈强链工作计划》。明确构建“一核多极”格局:南溪区主攻竹浆纸,长宁县聚焦竹食品,兴文县发展“以竹代塑”制品......形成“主承载地+协同地”的产业矩阵,宜宾竹产业发展前景更加广阔。

兴文创新竹日用品交易中心竹制家具
与此同时,还将构建“宜泸乐眉”四市紧密协同、辐射带动川滇黔渝毗邻市(县)竹产业高质量发展格局,打造全国竹产业中小企业集群和科技创新高地。
强链:
从“卖制品”到“卖生态”的跨越发展

四川大江禾竹业有限公司(兴文县委宣传部供图)
从“大资源”到“强链条”的转型跨越,一条清晰地从传统竹制品到高端竹家具、竹基新材料,再到竹林碳汇交易的竹产业链已跃然于前......
在兴文经开区竹产业园内,四川大江禾竹业有限公司生产车间满负荷运转,形状不一的毛竹片经过碳化、浸胶、压制等全自动工艺,被加工为一块块重竹地板。该公司负责人吴特杰表示,精深加工后,这些家具市场中的高端产品,1立方米的市场价超过1万元,较大多数竹制产品至少高出1倍。

宜宾祥泰环保科技有限公司(兴文县委宣传部供图)
同样作为竹制品加工企业,宜宾祥泰环保科技有限公司总经理李海朝介绍到,从开年复工后,生产线一直处于满线状态,订单年前已至,产品主出口到欧美和日韩。
该企业是一家出口一次性竹纸浆模塑环保餐具和包装产品的民营企业,总投资约8.5亿元,占地约300亩。分两期建设,预计完全建成后年生产竹纸浆环保餐具达8万吨以上。
在江安县阳春工业园,四川天竹竹资源开发有限公司的生产线正24小时运转。据了解,该公司通过生物炼制技术,将竹材分解为浆粕、纤维素等产品,1吨竹子的附加值从传统加工的2000元提升至1万元。

长宁县丰富的竹资源
而作为一竿翠竹的“碳中和”使命,竹林中也隐藏着碳汇交易的“密码”。
早在三年前,长宁县国有林场就将“优质空气”卖给了2022国际竹业品牌博览会,完成了全省首单竹林碳汇交易。经专业机构核查,该届竹博会通过购买长宁县国有林场73.34吨碳汇减排量,抵消了大会碳排放,实现了碳中和。据相关专业人士测算,“每亩竹林年固碳量约1.5吨,未来碳汇收益可能超过竹材本身。”
竹精深加工、竹原料培育、“以竹代塑”、竹文旅融合......一条全覆盖、完整度高的竹产业高质量发展之路,宜宾一直走在全省前列。
截至目前,全市现有竹加工企业632家,“以竹代塑”企业42家,新培育现代竹林基地113.83万亩。
未来:
科技+政策 高质量书写竹产业“宜宾样本”
宜宾林竹产业研究院选育竹胚(陈倩 摄)
依托宜宾林竹产业研究院(成渝竹产业协同创新中心)等创新平台的设施设备和人才队伍优势,近年来,宜宾进一步加强与国际竹藤中心、中国林业科学研究院、南京林业大学等科研院校合作,加快推进由院士和知名专家领衔的“智慧竹业关键技术研究与集成示范”“竹浆纸一体化关键技术研究项目”等重点研发项目。今年已有5个竹产业项目列入“揭榜挂帅”需求清单,计划投资2790万元。
政策+资金活水也在涌入。市级财政设立1亿元竹产业专项资金,现代农业特色产业发展基金规模达10亿元,推出“惠林贷”等政策措施,强化用地、能耗等要素保障,提升竹加工园区承载能力和服务水平。
下一步,宜宾将持续推进建圈强链、圈链协同,以科技创新赋能产业发展和企业转型,紧盯竹产业新赛道,充分发挥龙头企业的带动作用,推动产业结构不断优化、产品不断升级,积极推广“以竹代塑”,让宜宾竹产品走进千家万户。

竹农丰收 (兴文县委宣传部供图)
从“靠山吃山”到“点竹成金”,宜宾的实践证明,绿水青山与金山银山可双向转化。随着“以竹代塑”纳入国家战略,这片川南竹海,已成为长江上游绿色经济的重要增长极。
记者获悉,就在本月下旬,将在宜举办2025国际竹业品牌博览会暨第二届中国竹浆纸产业发展大会,进一步搭建起全球竹产业发展的沟通交流桥梁,更让世界看见中国竹产业高质量发展的“宜宾篇章”!
来源:宜人宜宾